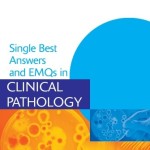

Aida Lai
Description
Anatomy and pathology are key areas in medical training, but the amount medical students have to learn within them can seem overwhelming. This book helps students gain a firm grasp of the facts they must know before they enter their clinical years. It encompasses the core basics of the major organ systems in the body and presents them in a memorable, easy-to-read form. The book covers the background and knowledge that are clinically relevant to, and commonly encountered in, end-of-semester exams and provides a solid preparation for clinical years. It is an excellent resource for all medical students wishing to gain and retain anatomy and pathology knowledge in a time-effective manner.show more
Download
Note: Only Gold member can download this ebook. Learn more here!